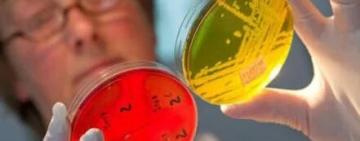
Детсад в Одесской области, где отравились дети, закрыли - подозревают золотистый стафилококк

Єрська Юлія
yerskaya@ukr.net
Освіта:Ізмаїльський ДГУ, філологічний факультет, українська мова та література
Детсад в Одесской области, где отравились дети, закрыли - подозревают золотистый стафилококк
Детский сад №12 в городе Черноморск временно приостановил работу - количество детей, отравившихся выросло.
В городе Черноморск Од...

Взрыв в Бейруте: предполагаемый владелец опасного груза — украинец
Расследование OCCRP (Центр по исследованию коррупции и организованной преступности) показало, что груз аммиачной селитры, взорвавшейся...

В Одесской области ночью поезд насмерть сбил 18-летнего парня
Полицейские Подольского района устанавливают обстоятельства смерти юноши на железной дороге.
По словам машиниста товарного пое...

В Тарутинской громаде на женщину напал бешеный хорек
Женщина, находясь в шоковом состоянии, убила животное.
В Болградском районе Одесской области бешеный хорек напал на женщину и по�...

Испытывал ружье: убийцей мужчины в Затоке оказался экс-депутат поссовета
Вчера, 19 сентября, в поселке Затока Одесской области, произошло ...

В Україні після вакцинації помер 19-річний студент
13 вересня ввечері помер Володимир Сало, студент 3 курсу спеціальності «Філологія» Українського гуманітарного інституту. Попередня д�...

В Болграде установили рекорд: улицы города укрыла гигантская дорожка с орнаментом (фото, видео)
В Книге рекордов Украины появилась еще одна запись в разделе «Размеры искусства» - это новый огромный стрит-арт в Болграде. На улицах �...

В одном из баров Затоки из охотничьего ружья был застрелен мужчина (фото, видео)
Полиция расследует убийство 36-летнего мужчины в поселке Затока Одесской области. Об этом сообщает отдел коммуникации полиции в Одесс...

Сніг цьогоріч буде швидко і надовго: з’явився точний прогноз погоди на жовтень і листопад
Перший місяць осені на половину пройшов, і поки що все не так страшно. Гарна погода по всій території України, тепло, відсутність опаді...





